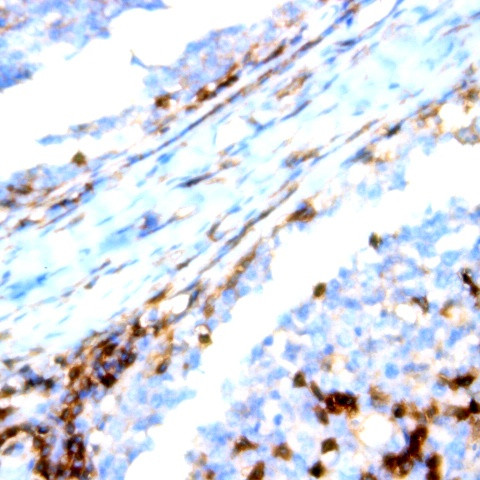
CD195/CCR5 Antibody in Immunohistochemistry (Paraffin) (IHC (P))

Search
AbboMax
CD195/CCR5 Monoclonal Antibody (HEK1)
{{$productOrderCtrl.translations['antibody.pdp.commerceCard.promotion.promotions']}}
{{$productOrderCtrl.translations['antibody.pdp.commerceCard.promotion.viewpromo']}}
{{$productOrderCtrl.translations['antibody.pdp.commerceCard.promotion.promocode']}}: {{promo.promoCode}} {{promo.promoTitle}} {{promo.promoDescription}}. {{$productOrderCtrl.translations['antibody.pdp.commerceCard.promotion.learnmore']}}
图: 1 / 1
CD195/CCR5 Antibody (605-580) in IHC (P)

产品信息
605-580
种属反应
宿主/亚型
分类
类型
克隆号
抗原
偶联物
形式
浓度
纯化类型
保存液
内含物
保存条件
运输条件
产品详细信息
Positive control: Thymus
Cellular location: Membrane.
靶标信息
Human immunodeficiency virus (HIV) and related virus require coreceptors, in addition to CD4, to infect target cells. Some G protein-coupled receptors including CCR5, CXCR4, CCR3, CCR2b and CCR8 in the chemokine receptor family, and four new human molecules GPR15, STRL33, GPR1 and V28 were recently identified as HIV coreceptors. Among them, CCR5 (CC-CKR-5) is a principal coreceptor for macrophage- and dual-tropic HIV-1 strains fusion and entry of human white blood cells. CCR5 is required for the infection by HIV-1, HIV-2, and SIV. The beta-chemokines RANTES, MIP-alpha and MIP-beta are the ligands for CCR5 and prevent infection by M-tropic HIV-1. CCR5 associates with the surface CD4-gp120 of HIV complex and leads to membrane fusion and virus entry of target cells. The amino-terminal domain and the extracellular loops of CCR5 serve as HIV biding sites. CCR5 messenger RNA is expressed in lymphoid organs and monocytes.
仅用于科研。不用于诊断过程。未经明确授权不得转售。
篇参考文献 (0)
生物信息学
蛋白别名: C-C chemokine receptor type 5; C-C CKR-5; C-C motif chemokine receptor 5 A159A; CD195; CD195 antigen; chemokine (C-C motif) receptor 5; chemokine receptor CCR5; CHEMR13; HIV-1 fusion coreceptor
基因别名: CC-CKR-5; CCCKR5; CCR-5; CCR5; CD195; CKR-5; CKR5; CMKBR5; IDDM22
UniProt ID: (Human) P51681
Entrez Gene ID: (Human) 1234